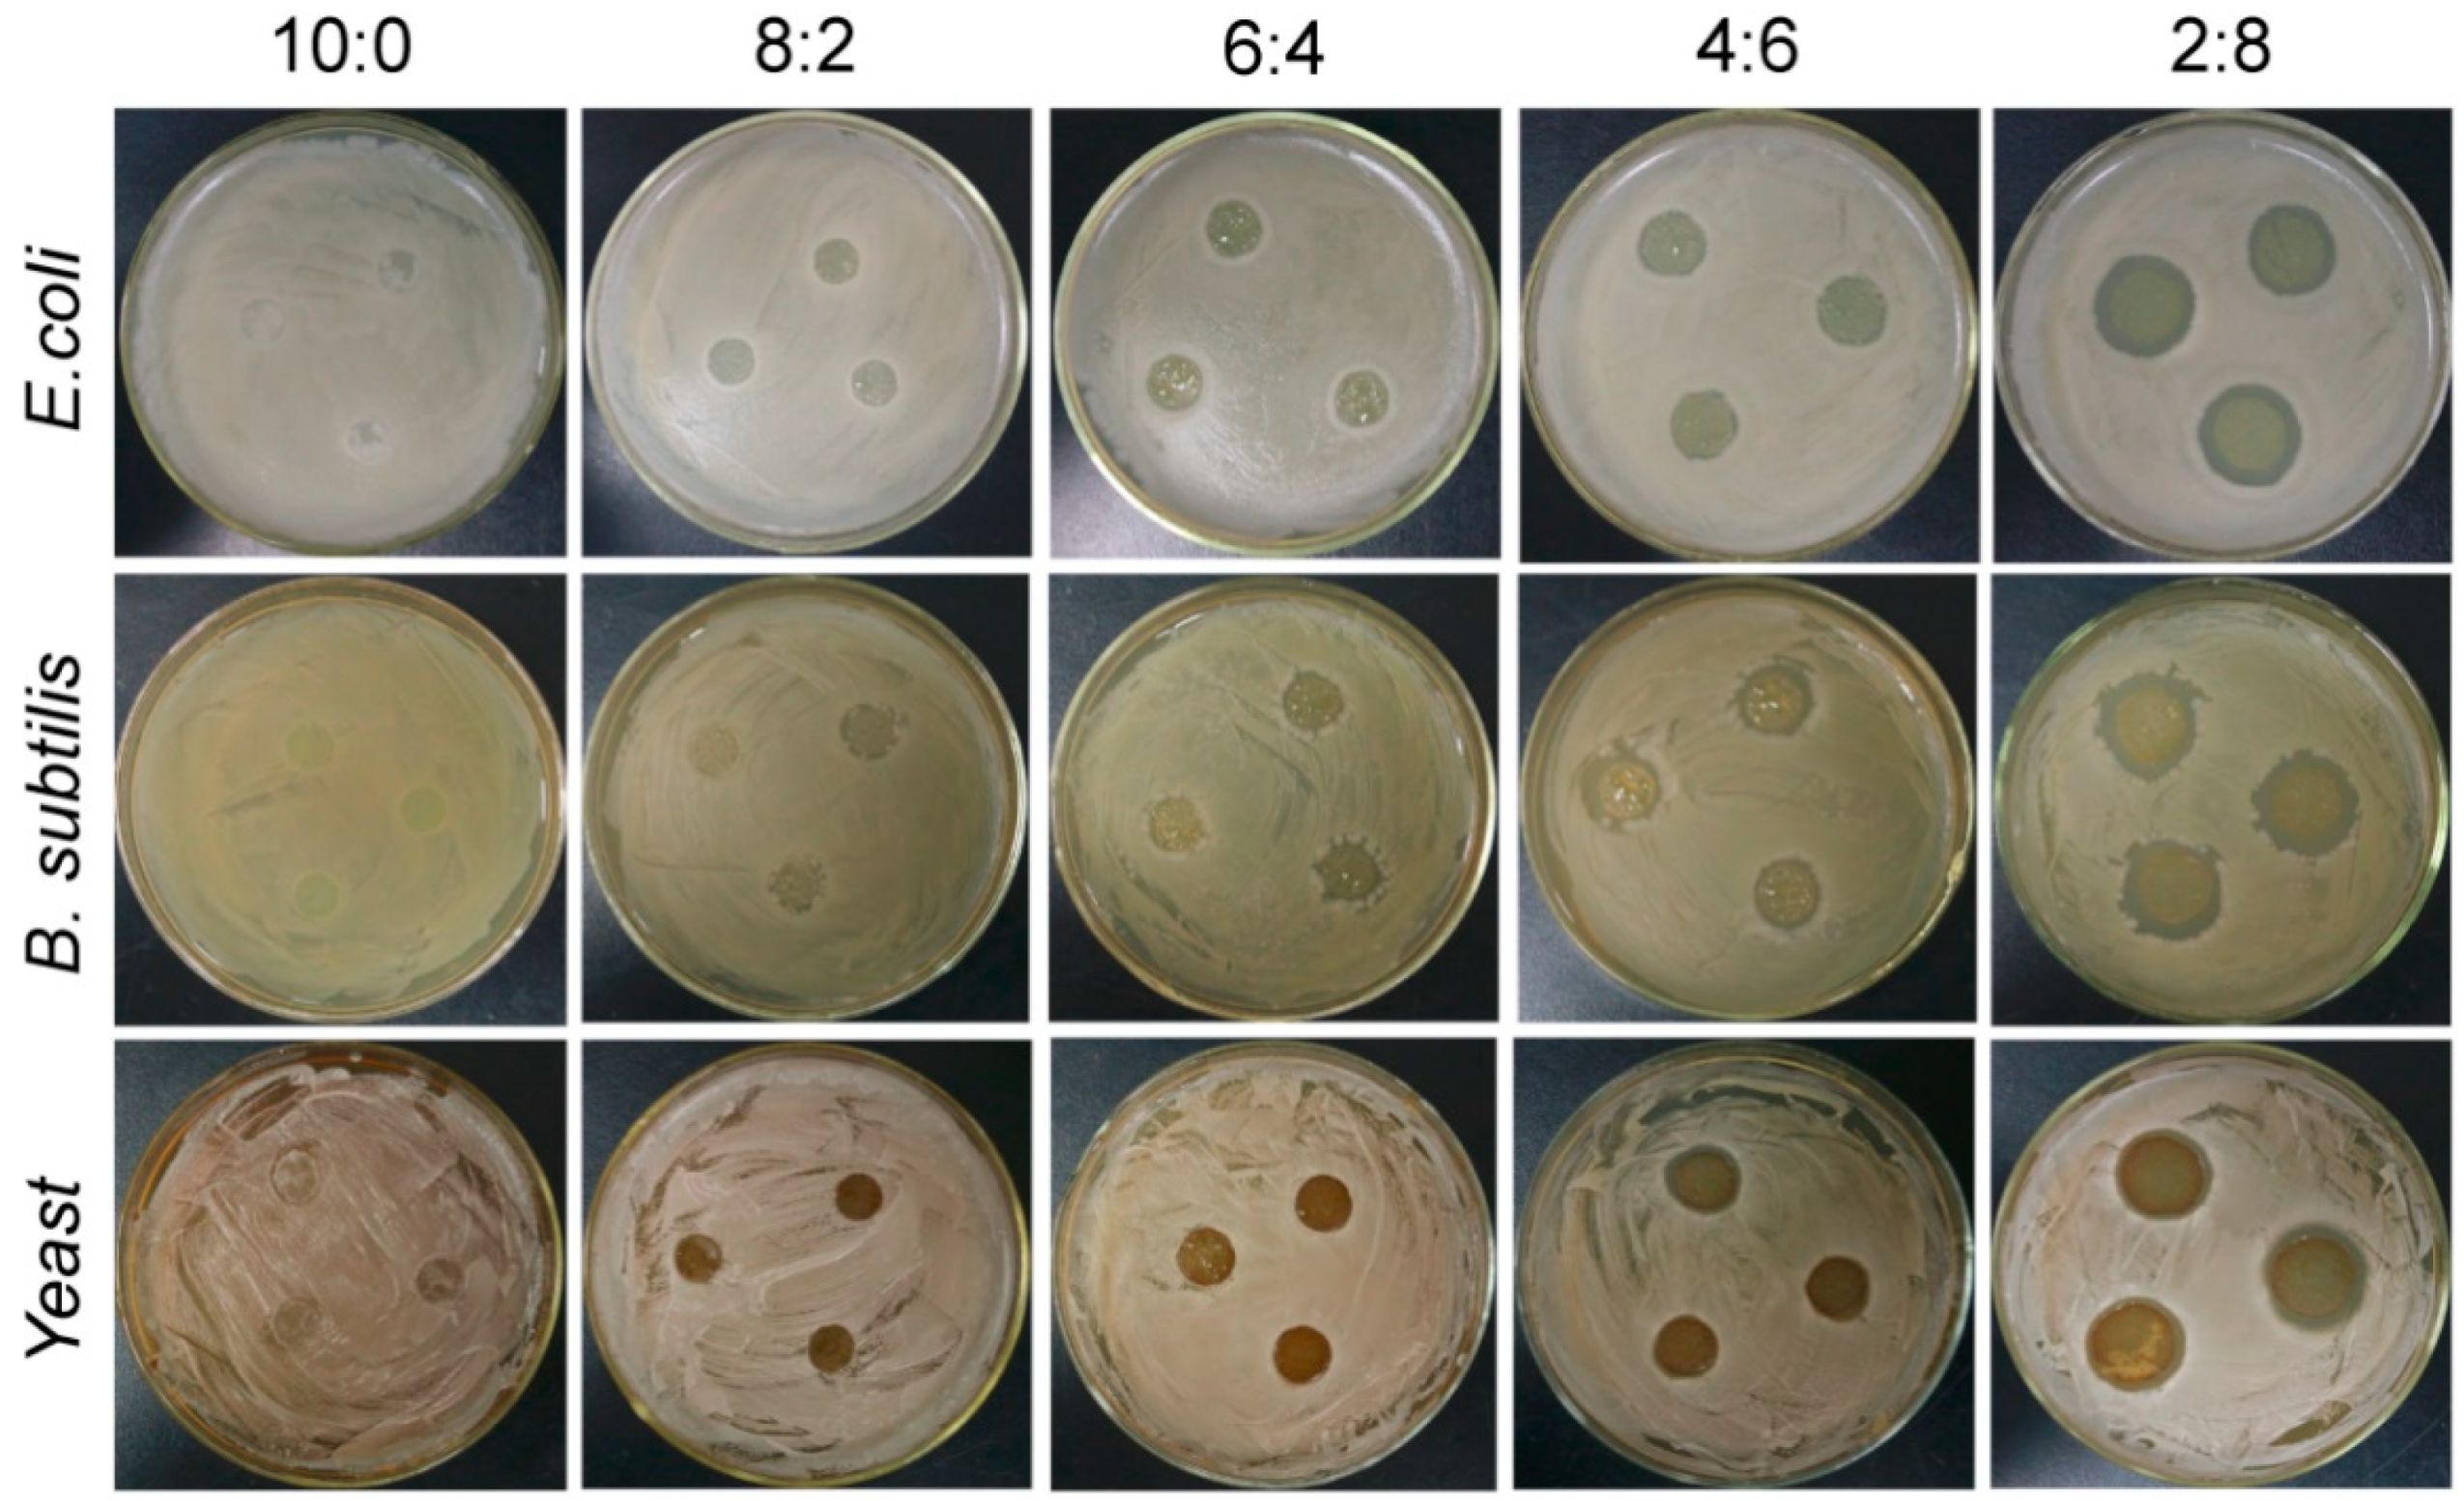
Materials 15 02327 g007 550

Preparation and Properties of Pea Starch/ε-Polylysine Composite Films
Abstract
:1. Introduction
2. Materials and Methods
2.1. Preparation of Composite Films
2.2. Measurement of Rheological Properties
2.3. Measurement of Mechanical Properties
2.4. Fourier Transformed INFRARED spectroscopy
2.5. Measurement of Water Vapor Permeability (WVP)
2.6. Measurement of Oil Permeability
2.7. Measurement of Thermogravimetry
2.8. SEM
2.9. Antibacterial Assays
3. Results and Discussion
3.1. Rheological Properties of the Composite Films
3.2. Mechanic Properties of the Composite Films
3.3. FTIR Spectra of the Composite Films
3.4. Gas Permeability of the Composite Films
3.5. Thermogravimetric Analysis of the Composite Films
3.6. SEM of the Composite Films
3.7. Antimicrobial Activities of the Composite Films
4. Conclusions
Author Contributions
Funding
Institutional Review Board Statement
Informed Consent Statement
Data Availability Statement
Acknowledgments
Conflicts of Interest
References
- Salah, A.A.M.; Mohamed, E.-S.; Mohamed, A.M.E.-S. Polysaccharides, protein and lipid-based natural edible films in food packaging: A review. Carbohydr. Polym. 2020, 238, 116178. [Google Scholar] [CrossRef]
- Zhang, W.L.; Zhang, Y.Q.; Cao, J.K.; Jiang, W.B. Improving the performance of edible food packaging films by using nanocellulose as an additive. Int. J. Biol. Macromol. 2021, 166, 288–296. [Google Scholar] [CrossRef] [PubMed]
- Yousuf, B.; Sun, Y.Q.; Wu, S.M. Lipid and lipid-containing composite edible coatings and films. Food Rev. Int. 2021, 33, 1–24. [Google Scholar] [CrossRef]
- Dinika, I.; Verma, D.K.; Balia, R.; Utama, G.L.; Patel, A.R. Potential of cheese whey bioactive proteins and peptides in the development of antimicrobial edible film composite: A review of recent trends. Trends Food Sci. Technol. 2020, 103, 57–67. [Google Scholar] [CrossRef]
- Kester, J.J.; Fennema, O.R. Edible films and coatings: A review. Food Tech. 1986, 60, 47–59. [Google Scholar] [CrossRef]
- Bastioli, C. Properties and applications of mater-bi starch-based materials. Polym. Degrad. Stab. 1998, 59, 263–272. [Google Scholar] [CrossRef]
- Li, M.; Liu, P.; Zou, W.; Yu, L.; Xie, F.W.; Pu, H.Y.; Liu, H.S.; Chen, L. Extrusion processing and characterization of edible starch films with different amylose contents. J. Food Eng. 2011, 106, 95–101. [Google Scholar] [CrossRef]
- Chaudhary, A.L.; Miler, M.; Torley, P.J.; Sopade, P.A.; Halley, P.J. Amylose content and chemical modification effects on thermoplastic starch from maize. Carbohydr. Polym. 2008, 74, 907–913. [Google Scholar] [CrossRef]
- González-Soto, R.A.; Núñez-Santiago, M.C.; Bello-Pérez, L.A. Preparation and partial characterization of films made with dual-modified (acetylation and crosslinking) potato starch. J. Sci. Food Agric. 2019, 99, 3134–3141. [Google Scholar] [CrossRef]
- Mehboob, S.; Ali, T.M.; Sheikh, M.; Hasnain, A. Effects of cross linking and/or acetylation on sorghum starch and film characteristic. Int. J. Biol. Macromol. 2020, 155, 786–794. [Google Scholar] [CrossRef]
- Gutiérrez, T.J.; Tapia, M.S.; Pérez, E.; Famá, L. Structural and mechanical properties of edible films made from native and modified cush-cush yam and cassava starch. Food Hydrocoll. 2015, 45, 211–217. [Google Scholar] [CrossRef]
- Talja, R.A.; Helén, H.; Roos, Y.H.; Jouppila, K. Effect of various polyols and polyol contents on physical and mechanical properties of potato starch-based films. Carbohydr. Polym. 2007, 67, 288–295. [Google Scholar] [CrossRef]
- Petersson, M.; Stading, M. Water vapour permeability and mechanical properties of mixed starch-monoglyceride films and effect of film forming conditions. Food Hydrocoll. 2005, 19, 123–132. [Google Scholar] [CrossRef]
- Patil, S.; Bharimalla, A.K.B.; Mahapatra, A.; Arputharaj, A.J.D.-L.; Kumar, M.; Raja, A.S.M.; Kambli, N. Effect of polymer blending on mechanical and barrier properties of starch-polyvinyl alcohol based biodegradable composite films. Food Biosci. 2021, 44, 101352. [Google Scholar] [CrossRef]
- Huntrakul, K.; Yoksan, R.; Sane, A.; Harnkarnsujarit, N. Effects of pea protein on properties of cassava starch edible films produced by blown-film extrusion for oil packaging. Food Packag. Shelf Life 2020, 24, 100480. [Google Scholar] [CrossRef]
- Mir, S.; Yasin, T.; Halley, P.J.; Siddiqi, H.M.; Ozdemir, O.; Nguyen, A. Thermal and rheological effects of sepiolite in linear low-density polyethylene/starch blend. J. Appl. Polym. Sci. 2013, 127, 1330–1337. [Google Scholar] [CrossRef]
- Sabetzadeh, M.; Bagheri, R.; Masoomi, M. Effect of oxidized starch on morphology, rheological and tensile properties of low-density polyethylene/linear low-density polyethylene/thermoplastic oxidized starch blends. J. Polym. Environ. 2018, 26, 2219–2226. [Google Scholar] [CrossRef]
- Mazerolles, T.; Heuzey, M.-C.; Soliman, M.; Martens, H.; Kleppinger, R.; Huneault, M.A. Development of multilayer barrier films of thermoplastic starch and low-density polyethylene. J. Polym. Res. 2020, 27, 44. [Google Scholar] [CrossRef]
- Shima, S.; Sakai, H. Poly-l-lysine produced by Streptomyces. Part II. Taxonomy and fermentation studies. Agric. Biol. Chem. 1981, 45, 2497–2502. [Google Scholar] [CrossRef]
- Chang, S.S.; Lu, W.Y.; Park, S.H.; Kang, D.H. Control of foodborne pathogens on ready-to-eat roast beef slurry by ε-polylysine. Int. J. Food Microbiol. 2010, 141, 236–241. [Google Scholar] [CrossRef]
- Tsujita, T.; Takaichi, H.; Takaku, T.; Aoyama, S.; Hiraki, J. Antiobesity action of -polylysine, a potent inhibitor of pancreatic lipase. J. Lipid Res. 2006, 47, 1852–1858. [Google Scholar] [CrossRef] [PubMed] [Green Version]
- Choi, J.S.; Joo, D.K.; Kim, C.H.; Kim, K.; Park, J.S. Synthesis of a barbell-like triblock copolymer, poly (L-lysine) dendrimer, and its self-assembly with plasmid DNA. J. Am. Chem. Soc. 2000, 122, 474–480. [Google Scholar] [CrossRef]
- Yu, Z.L.; Rao, G.W.; Wei, Y.X.; Yu, J.; Wu, S.H.; Fang, Y.P. Preparation, characterization, and antibacterial properties of biofilms comprising chitosan and ε-polylysine. Int. J. Biol. Macromol. 2019, 141, 545–552. [Google Scholar] [CrossRef] [PubMed]
- Karimi, M.; Yazdi, F.T.; Mortazavi, S.A.; Shahabi-Ghahfarrokhi, I.; Chamani, J. Development of active antimicrobial poly (l-glutamic) acid-poly (l-lysine) packaging material to protect probiotic bacterium. Polym. Test 2020, 83, 106338. [Google Scholar] [CrossRef]
- Huang, M.; Wang, H.; Xu, X.; Lu, X.; Song, X.; Zhou, G. Effects of nanoemulsion-based edible coatings with composite mixture of rosemary extract and ε-poly-L-lysine on the shelf life of ready-to-eat carbonado chicken. Food Hydrocoll. 2019, 102, 105576. [Google Scholar] [CrossRef]
- Razavi, R.; Tajik, H.; Moradi, M.; Molaei, R.; Ezati, P. Antimicrobial, microscopic and spectroscopic properties of cellulose paper coated with chitosan sol-gel solution formulated by epsilon-poly-l-lysine and its application in active food packaging. Carbohydr. Res. 2020, 489, 107912. [Google Scholar] [CrossRef]
- Zhang, L.; Li, R.; Dong, F.; Tian, A.; Li, Z.; Dai, Y. Physical, mechanical and antimicrobial properties of starch films incorporated with epsilon-poly-L-lysine. Food Chem. 2015, 166, 107–114. [Google Scholar] [CrossRef]
- Wei, Y.; Huang, Z.; Yu, Z.; Han, C.; Yang, C. Preparation and properties of fractionated soybean protein isolate films. Materials 2021, 14, 5436. [Google Scholar] [CrossRef]
- Mirzaei-Mohkam, A.; Garavand, F.; Dehnad, D.; Keramat, J.; Nasirpour, A. Physical, mechanical, thermal and structural characteristics of nanoencapsulated vitamin E loaded carboxymethyl cellulose films. Prog. Org. Coat. 2020, 138, 105383. [Google Scholar] [CrossRef]
- Witczak, T.; Witczak, M.; Ziobro, R. Effect of inulin and pectin on rheological and thermal properties of potato starch paste and gel. J. Food Eng. 2014, 124, 72–79. [Google Scholar] [CrossRef]
- Liu, M.; Mao, Z.; Jiang, X.; Yu, C.; Niu, Y.; Zhou, Y. Properties of chitosan film-forming solution and its films. Food Sci. 2014, 35, 11–15. [Google Scholar] [CrossRef]
- Maeda, S.; Kunimoto, K.-K.; Sasaki, C.; Kuwae, A.; Hanai, K. Characterization of microbial poly (ε-L-lysine) by FT-IR, Raman and solid state 13C NMR spectroscopies. J. Mol. Struct. 2003, 655, 149–155. [Google Scholar] [CrossRef]
- Zhong, Y.; Li, Y.; Qu, J.; Zhang, X.; Seytahmetovna, S.A.; Blennow, A.; Guo, D. Structural features of five types of maize starch granule subgroups sorted by flow cytometry. Food Chem. 2021, 356, 129657. [Google Scholar] [CrossRef] [PubMed]
- Gao, W.; Zhu, J.; Kang, X.; Wang, B.; Liu, P.; Cui, B.; EI-Aty, A.M. Development and characterization of starch films prepared by extrusion blowing: The synergistic plasticizing effect of water and glycerol. LWT-Food Sci. Technol. 2021, 148, 111820. [Google Scholar] [CrossRef]
- Tang, Q.; Pan, D.; Sun, Y.; Cao, J.; Zeng, X.; Wu, Z. Preparation and performance of antimicrobial films based on sodium alginate and ε-poly-L-lysine. J. Chin. Inst. Food Sci. Technol. 2016, 16, 101–107. [Google Scholar] [CrossRef]
- Liu, W.; Zhou, T. Action mechanism of antimicrobial ε-poly-L-lysine. Food Sci. 2009, 30, 15–20. [Google Scholar] [CrossRef]
- Liu, H.; Pei, H.; Han, Z.; Feng, G.; Li, D. The antimicrobial effects and synergistic antibacterial mechanism of the combination of ε-Polylysine and nisin against Bacillus subtilis. Food Control 2015, 47, 444–450. [Google Scholar] [CrossRef]
- Shao, Z.; Yang, Y.; Fang, S.; Li, Y.; Chen, J.; Meng, Y. Mechanism of the antimicrobial activity of whey protein-ε-polylysine complexes against Escherichia coli and its application in sauced duck products. Int. J. Food Microbiol. 2020, 328, 108663. [Google Scholar] [CrossRef] [PubMed]

| Diameter of the Antibacterial Zone (cm) | |||||
|---|---|---|---|---|---|
| 10:0 | 8:2 | 6:4 | 4:6 | 2:8 | |
| E. coli | 0 | 1.00 | 1.18 ± 0.07 | 1.40 ± 0.10 | 1.98 ± 0.18 |
| B. subtilis | 0 | 1.2 ± 0.10 | 1.67 ± 0.07 | 1.83 ± 0.13 | 2.33 ± 0.13 |
| Yeast | 0 | 1.00 | 1.28 ± 0.05 | 1.45 ± 0.15 | 2.18 ± 0.08 |
Publisher’s Note: MDPI stays neutral with regard to jurisdictional claims in published maps and institutional affiliations. |
© 2022 by the authors. Licensee MDPI, Basel, Switzerland. This article is an open access article distributed under the terms and conditions of the Creative Commons Attribution (CC BY) license (https://creativecommons.org/licenses/by/4.0/).
Share and Cite
Yu, Z.; Gong, D.; Han, C.; Wei, Y.; Fu, C.; Xu, X.; Lu, Y. Preparation and Properties of Pea Starch/ε-Polylysine Composite Films. Materials 2022, 15, 2327. https://doi.org/10.3390/ma15062327
Yu Z, Gong D, Han C, Wei Y, Fu C, Xu X, Lu Y. Preparation and Properties of Pea Starch/ε-Polylysine Composite Films. Materials. 2022; 15(6):2327. https://doi.org/10.3390/ma15062327
Chicago/Turabian StyleYu, Zuolong, Deping Gong, Chao Han, Yunxiao Wei, Changchun Fu, Xuejiao Xu, and Youri Lu. 2022. "Preparation and Properties of Pea Starch/ε-Polylysine Composite Films" Materials 15, no. 6: 2327. https://doi.org/10.3390/ma15062327
APA StyleYu, Z., Gong, D., Han, C., Wei, Y., Fu, C., Xu, X., & Lu, Y. (2022). Preparation and Properties of Pea Starch/ε-Polylysine Composite Films. Materials, 15(6), 2327. https://doi.org/10.3390/ma15062327

